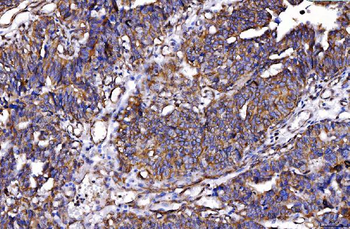
HGS Antibody (monoclonal, 4B7E2)
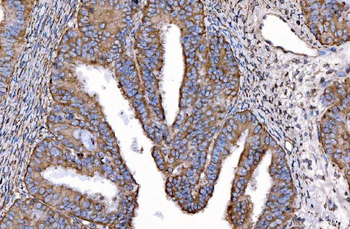
HGS Antibody (monoclonal, 4B7E2)
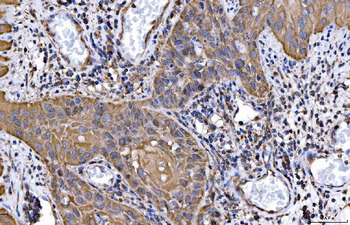
HGS Antibody (monoclonal, 4B7E2)
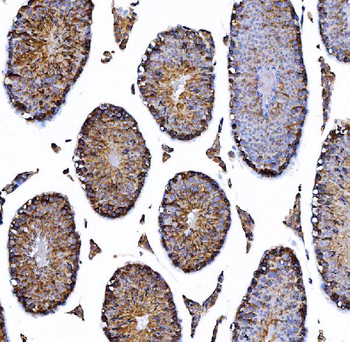
HGS Antibody (monoclonal, 4B7E2)
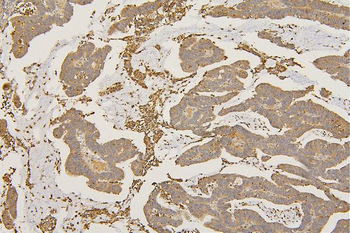
SFRP1 Antibody
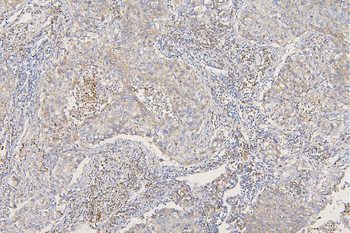
SFRP1 Antibody
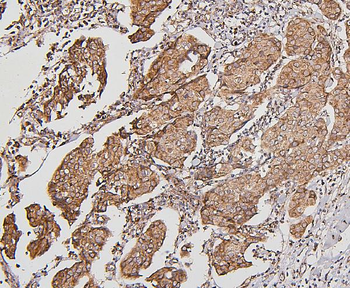
BAK/BAK1 Antibody (monoclonal, 4C2)

You have no items in your shopping cart.
- AIFM1 Antibody [orb1239169]Featured

ELISA, IHC-P, WB
Human, Mouse, Rat
Rabbit
Polyclonal
Unconjugated
0.1 mg, 0.02 mg - HGS Antibody (monoclonal, 4B7E2) [orb1145858]
FC, ICC, IF, IHC, WB
Human, Mouse, Rat
Mouse
Monoclonal
Unconjugated
100 μg - Caspase-3 Recombinant Rabbit Monoclonal Antibody [orb2563024]Featured

IF, IHC-Fr, IHC-P, WB
Human, Mouse, Rat
Mouse, Rat
Rabbit
Recombinant
Unconjugated
25 μl, 50 μl, 100 μl - Bad Recombinant Rabbit Monoclonal Antibody [orb559060]
ICC, IF, IHC-Fr, IHC-P, WB
Human, Rat
Mouse
Rabbit
Recombinant
Unconjugated
50 μl, 100 μl - Fas Ligand Rabbit Polyclonal Antibody [orb221406]Featured

FC, IF, IHC-Fr, IHC-P, WB
Human, Mouse, Rat
Bovine
Rabbit
Polyclonal
Unconjugated
50 μl, 100 μl, 200 μl - SFRP1 Antibody [orb527039]
ELISA, FC, ICC, IF, IHC, WB
Human, Mouse, Rat
Rabbit
Polyclonal
Unconjugated
100 μg - BAK/BAK1 Antibody (monoclonal, 4C2) [orb570309]
FC, ICC, IF, IHC, WB
Human, Mouse, Rat
Mouse
Monoclonal
Unconjugated
100 μg - ASC/TMS1 Rabbit Polyclonal Antibody [orb100371]Featured

WB
Human
Bovine, Canine, Equine, Porcine, Rabbit
Rabbit
Polyclonal
Unconjugated
50 μl, 100 μl, 200 μl - Featured

FC, ICC, IF, IHC-Fr, IHC-P, WB
Human, Mouse, Rat
Bovine, Canine, Gallus, Porcine, Rabbit, Sheep
Rabbit
Polyclonal
Unconjugated
100 μl, 50 μl, 200 μl - Featured

IF, IHC-Fr, IHC-P, WB
Human, Mouse, Rat
Bovine, Canine, Gallus, Porcine, Rabbit, Sheep
Rabbit
Polyclonal
Unconjugated
200 μl, 100 μl, 50 μl